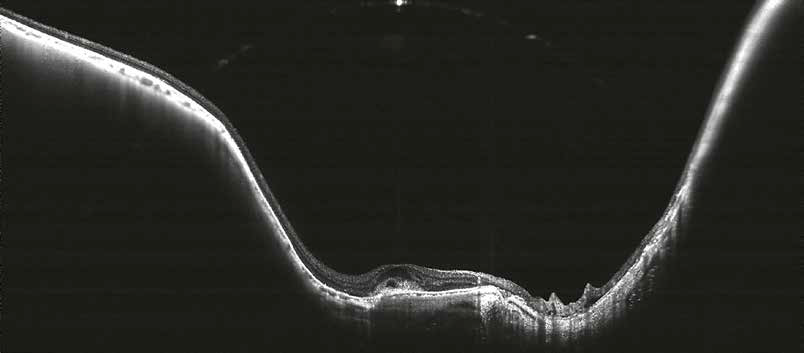

Wide-Field, Deep Tissue Imaging
The Canon Xephilio OCT-S1 uses swept-source OCT technology to provide wide-field imaging of up to 23 mm in a single scan, corresponding to an approximately 80° viewing angle. This enables comprehensive visualization of both central and peripheral retinal structures in one acquisition.
With an imaging depth of up to 5.3 mm, the system allows detailed visualization of deeper ocular structures, including the vitreous body and choroid, with improved penetration and reduced signal scatter. A scanning speed of 100,000 A-scans per second supports fast acquisition and high-resolution imaging with reduced motion artifacts.
The swept-source technology enhances penetration into deeper tissue layers such as the choroid and sclera, supporting improved structural visualization in complex cases. This enables more complete assessment of posterior segment anatomy within a single scan.
Wide-field 23 mm scan demonstrating chronic central retinal vein occlusion with associated macular edema.
The retinal curvature, including posterior staphyloma, is clearly visualized in this case of myopic choroidal neovascularization (mCNV), enabled by the 5.3 mm imaging depth.
Versatile reporting possibilities
The Xephilio OCT-S1 supports comprehensive reporting workflows with extensive DICOM and EMR compatibility. Imaging data can be stored, shared, and integrated into existing clinical systems, supporting efficient documentation and multidisciplinary collaboration.
3D Reporting
OCT-A Reporting